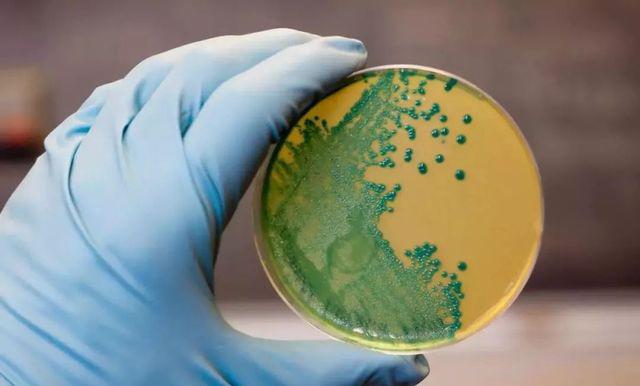
Từ vụ mẹ mất con do ăn hoa quả trong tủ lạnh, cẩn thận loại vi khuẩn không sợ lạnh

-
 Tử vi 12 con giáp - Chủ nhật ngày 21/6/2026: Ngọ tiến bộ, Thìn mát vía
Tử vi 12 con giáp - Chủ nhật ngày 21/6/2026: Ngọ tiến bộ, Thìn mát vía -
 Sập bẫy "hợp đồng kỳ nghỉ": Người phụ nữ bị nhóm nhân viên Meli Club phối hợp "bào" sạch 5 tỷ đồng
Sập bẫy "hợp đồng kỳ nghỉ": Người phụ nữ bị nhóm nhân viên Meli Club phối hợp "bào" sạch 5 tỷ đồng -
 Tìm thấy nữ sinh lớp 7 mất tích sau cuộc gọi “khóc nấc” bất thường
Tìm thấy nữ sinh lớp 7 mất tích sau cuộc gọi “khóc nấc” bất thường -
 Nhận định bóng đá Đức vs Bờ Biển Ngà: Đức dễ áp đảo
Nhận định bóng đá Đức vs Bờ Biển Ngà: Đức dễ áp đảo -
 Người phụ nữ Việt Nam đưa súng cho chồng vượt ngục trước cổng tòa án ở Campuchia chính thức lĩnh án
Người phụ nữ Việt Nam đưa súng cho chồng vượt ngục trước cổng tòa án ở Campuchia chính thức lĩnh án -
 Người phụ nữ bị hai con sán dài 10 cm “làm tổ” trong tay vì thói quen dùng chung dao thớt
Người phụ nữ bị hai con sán dài 10 cm “làm tổ” trong tay vì thói quen dùng chung dao thớt -
 Phẫn nộ tài khoản xe ôm công nghệ chụp lén phụ nữ, thách thức dư luận
Phẫn nộ tài khoản xe ôm công nghệ chụp lén phụ nữ, thách thức dư luận -
 Bàng hoàng phát hiện thi thể bé gái sơ sinh trong chiếc túi xách bỏ trước cổng chùa
Bàng hoàng phát hiện thi thể bé gái sơ sinh trong chiếc túi xách bỏ trước cổng chùa -
 Đối tượng dùng hung khí chém tài xế tại chung cư New Horizon ra đầu thú sau 5 ngày lẩn trốn
Đối tượng dùng hung khí chém tài xế tại chung cư New Horizon ra đầu thú sau 5 ngày lẩn trốn -
 Nữ thủ khoa lớp 10 Hà Nội năm 2026 từng đạt giải Nhất học sinh giỏi Văn
Nữ thủ khoa lớp 10 Hà Nội năm 2026 từng đạt giải Nhất học sinh giỏi Văn
Gia đình
17/08/2018 22:49Từ vụ mẹ mất con do ăn hoa quả trong tủ lạnh, cẩn thận loại vi khuẩn 'không sợ lạnh'
Thai phụ 20 tuổi ăn hoa quả trong tủ lạnh, khiến thai nhi chết lưu
Theo tin tức tờ Qianjiang Evening News, một bà mẹ trẻ 20 tuổi ở Chiết Giang, Trung Quốc tên Hiểu Mẫn, đã bị mất con khi chưa kịp chào đời do đã từng ăn hoa quả lấy ra ở trong tủ lạnh và chưa được rửa sạch, dẫn đến nhiễm vi khuẩn Listeria Monocytogenes.
Biểu hiện ban đầu của cô chỉ là cơn sốt, kèm theo đau đầu, không có biểu hiện khó chịu nào khác, nhưng tình trạng này kéo dài vài ngày. Sau khi đi khám mới biết thai nhi chết lưu.

Vi khuẩn Listeria Monocytogenes là gì?
Vi khuẩn Listeria monocytogenes là một trong 4 tác nhân gây bệnh do thực phẩm, được Tổ chức Y tế Thế giới công nhận, những vi khuẩn này được tìm thấy thường xuyên nhất là ở thịt nấu chưa chín, trong các sản phẩm từ sữa, hoa quả… nó phát triển tốt ở nhiệt độ từ 4°C-10°C. Nhiễm khuẩn Listeria monocytogenes là một bệnh truyền nhiễm nghiêm trọng.
Nhiệt độ của tủ lạnh thường là 2°C - 8°C, ở nhiệt độ này, hầu hết vi khuẩn khó phát triển tích cực, nhưng vi khuẩn Listeria monocytogenes "không sợ lạnh", có thể phát triển mạnh trong tủ lạnh. Hầu hết những người bị nhiễm Listeria monocytogenes có thể tìm thấy loại vi khuẩn này ở thức ăn đặt trong tủ lạnh.
Những dấu hiệu và triệu chứng của nhiễm khuẩn Listeria?
Với những người khoẻ mạnh, khi ăn phải thức ăn bị nhiễm Listeria monocytogenes, vi khuẩn không gây nên bất kỳ triệu chứng nào. Một số người có thể xuất hiện triệu chứng giống cảm cúm với các biểu hiện như sốt, đau cơ, buồn nôn, nôn, tiêu chảy và đau dạ dày, nếu như tiêu thụ thức ăn bị nhiễm một số lượng lớn vi khuẩn.
Vi khuẩn có thể vào máu gây nên tình trạng nhiễm khuẩn huyết. Nếu vi khuẩn xâm nhập vào hệ thần kinh, sẽ gây nên tình trạng viêm não màng não, với các biểu hiện: đau đầu, cứng cổ, động kinh, mất thăng bằng và cảm thấy bối rối hoặc mất phương hướng có thể xảy ra.

Trong trường hợp người cao tuổi, phụ nữ mang thai, người bị ung thư, người bị tiểu đường, bệnh thận giai đoạn cuối, bệnh gan, cấy ghép nội tạng và những người bị suy giảm miễn dịch, hậu quả của nhiễm Listeria monocytogenes có thể rất nghiêm trọng. Đặc biệt đối với phụ nữ có thai, vi khuẩn Listeria monocytogenes có thể qua nhau thai gây sảy thai, thai nhi chết lưu, gây sinh non, hoặc thai nhi chết ngay sau khi sinh.
Tỷ lệ mắc bệnh Listeria monocytogenes được chẩn đoán trong phòng thí nghiệm là 0,29 trường hợp/100.000 người, tỷ lệ mắc của phụ nữ mang thai là 3,0 trường hợp/100.000 người, và tỷ lệ tử vong là khoảng 16%.

Phụ nữ mang thai và bệnh nhân có chức năng miễn dịch giảm nên tránh các loại thực phẩm bao gồm: Sữa tươi, phô mai mềm, xúc xích, thịt nguội, hải sản xông khói, rau quả tươi, tôm, cua, bắp cải trộn…
Ngoài ra, những người khỏe mạnh cũng nên chú ý đến những vấn đề sau
1. Tránh ăn sữa và pho mát không tiệt trùng và các loại thực phẩm được làm từ chúng;
2. Rửa kỹ trái cây và rau củ trước khi ăn;
3. Đặt ngăn mát dưới 4,4 độ C và ngăn tủ đông dưới -18 độ C;
4. Hãy chắc chắn thịt và hải sản phải được nấu chín;
5. Rửa tay, dao và thớt sau khi tiếp xúc với thực phẩm sống.
Cần lưu ý khi dự trữ thực phẩm trong tủ lạnh

- Phải có những khoảng trống giữa các hộp thực phẩm để đảm báo không khí lưu thông;
- Thực phẩm nấu chín và thực phẩm sống phải để vào từng hộp riêng, tránh nhiễm khuẩn chéo;
- Thường xuyên lau chùi và khử trùng tủ lạnh;
- Các thực phẩm lưu trữ trong tủ lạnh cần được làm nóng trước khi ăn;
- Thời gian lưu trữ thực phẩm sống đông lạnh không nên vượt quá một tuần để tránh hiện tượng thực phẩm bị biến chất, nhiễm khuẩn gây ngộ độc.
Một số thực phẩm không thích hợp để trong tủ lạnh

Xoài, chuối: nhiệt độ quá thấp có thể khiến chúng "đông lạnh";
Khoai môn, bánh mì: Đặt nó trong tủ lạnh sẽ tăng tốc độ sấy khô và cứng của nó, dinh dưỡng và hương vị sẽ không được tốt như nhiệt độ bình thường;
Trà, sữa bột: Những loại thực phẩm này có thể được bảo quản ở nhiệt độ phòng, để trong tủ lạnh dễ hấp thu mùi, độ ẩm và khiến thực phẩm bị mốc và hư hỏng.
Thuốc: Thuốc để lẫn với các loại thực phẩm khác trong tủ lạnh dễ bị ẩm, ảnh hưởng đến hiệu quả của thuốc. Tốt nhất là nên bảo quản theo hướng dẫn của nhà sản xuất.
Theo Hà Vũ (Khampha.vn)








- Tin mới vụ 4 người chết ở Bắc Ninh: Nghi phạm đã chết, ai là người bồi thường cho gia đình nạn nhân? (28 phút trước)
- Giá vàng đối mặt áp lực mới sau thông điệp cứng rắn từ Fed (28 phút trước)
- Dân Brazil sốc nặng vì nhận tin nhắn cảnh báo "người ngoài hành tinh tấn công" (31 phút trước)
- 9 người cùng nhập viện sau bữa tiết canh, bác sĩ cảnh báo nguy cơ từ món ăn sống (36 phút trước)
- Lời kể nghẹn lòng từ hiện trường vụ thảm án ở Bắc Ninh: “Chúng tôi cố cứu các cháu nhưng đã quá muộn” (41 phút trước)
- Nhận định bóng đá Uruguay vs Cape Verde: Đại diện châu Phi có thể gây bất ngờ (1 giờ trước)
- Chiếc iPhone được cộng đồng công nhận là "siêu phẩm", tuy cũ nhưng đáng mua hơn iPhone 17 Pro Max (1 giờ trước)
- Doraemon chính thức cán mốc 200 tỷ đồng, thiết lập kỷ lục tại rạp Việt (1 giờ trước)
- Tài xế lên cơn nhồi máu cơ tim vẫn đạp phanh giữ an toàn cho hành khách trước khi qua đời (1 giờ trước)
- Khoảnh khắc mái đền đang xây dựng bất ngờ đổ sập khiến hàng chục người thương vong (1 giờ trước)
Bài đọc nhiều















